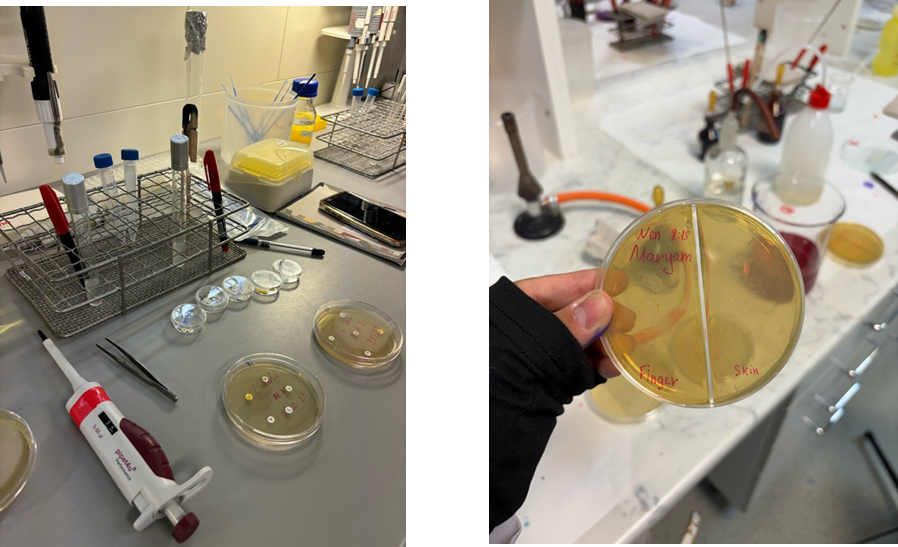

- Main
- News
- : Report on Academic Mobility in Hungary aligned with the 17 UN Sustainable Development Goals and the acquired academic and laboratory experience
: Report on Academic Mobility in Hungary aligned with the 17 UN Sustainable Development Goals and the acquired academic and laboratory experience
I, Nurakhunova Maryam Marksovna, participated in an academic mobility program in Hungary, in the city of Gödöllő, at the Hungarian University of Agriculture and Life Sciences (MATE) from 6 September to 29 January (duration — 5 months).
Within the academic mobility program, I studied at a foreign university and completed a range of fundamental and applied biological disciplines, including zoology, botany, molecular genetics, microbiology, plant physiology, and animal physiology. The program included both theoretical classes and intensive laboratory training, which significantly expanded my professional knowledge and practical skills.
1. Molecular Genetics
During the course “Molecular Genetics,” special attention was given to laboratory methods for nucleic acid analysis. In practical classes, I learned and practiced the following methods and procedures:
-
polymerase chain reaction (PCR);
-
gel electrophoresis for DNA analysis;
-
sample preparation and working with laboratory reagents;
-
use of micropipettes, centrifuges, thermocyclers, and other laboratory equipment.
As a result, I developed confident skills in working with modern molecular biology equipment, learned to follow laboratory safety rules, and gained experience in accurate interpretation of experimental results.

2. Microbiology
As part of the “Microbiology” course, we studied the main groups of microorganisms, as well as the mechanisms of action of antibiotics and their effects on bacteria. Laboratory sessions included:
-
experiments on bacterial sensitivity to antibiotics;
-
work with bacterial cultures;
-
analysis of microorganism growth;
-
maintaining sterile conditions and complying with biosafety rules.
This course provided a deeper understanding of the role of microorganisms in nature and medicine and helped me develop practical microbiological research skills.
3. Plant Physiology
During the study of plant physiology, we investigated vital processes in plants at the cellular and physiological levels. Practical work involved the following methods and instruments:
-
a spectrophotometer for analyzing the content of various substances;
-
instruments for measuring indicators related to light refraction and absorption;
-
studying the effects of various mutagens on plant growth and development;
-
analysis of plant chemical composition and the percentage ratio of major components.
These classes contributed to the development of experimental skills and the ability to analyze physiological processes in plants.

4. Animal Physiology
Within the “Animal Physiology” course, key physiological processes were studied using animal organisms as examples. Practical classes included:
-
analysis of blood properties;
-
study of hemoglobin and its functions;
-
laboratory work using chicken and rat as model organisms.
These sessions helped me better understand the mechanisms of animal body functioning and the interconnection of physiological processes.

Conclusion
Participating in the academic mobility program in Hungary was a valuable academic and practical experience for me. I significantly deepened my knowledge in biology, acquired new laboratory skills, learned to work with modern equipment, and adapted to an international educational environment. The experience gained will be useful for my further studies and professional development.
Department of Botany and Agroecology